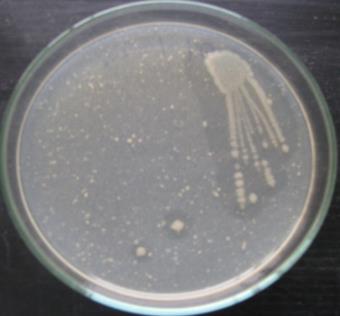
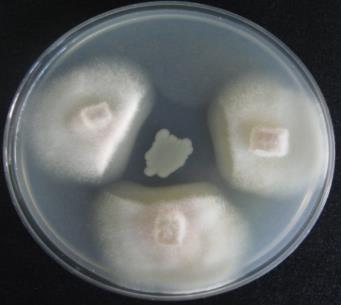
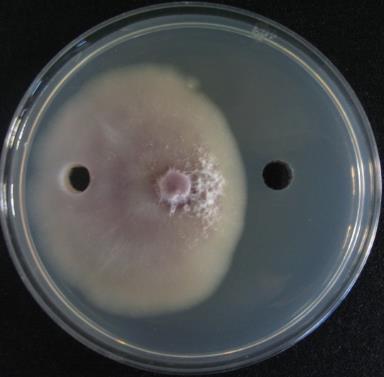

Department of Biotechnology, School of Bioengineering, SRM University, Chennai, Tamil Nadu, India
Email: velusamy.p@ktr.srmuniv.ac.in
Received: 19 Apr 2014 Revised and Accepted: 26 May 2014
ABSTRACT
Objective: Chitinase plays an important role against fungal pathogen and is a hopeful solution against fungal diseases. The main of this research is to screen a chitin degrading strain which can significantly used as biocontrol agent against Fusarium oxysporum.
Methods: In the present study, chitinase producing bacteria were isolated from soil sample of crop field and identified based on biochemical observation and 16S rRNA analysis. The molecular weight of the enzyme was determined by zymogram. The purified enzyme from identified strain JD-09 was tested for antagonistic activity against Fusarium oxysporum.
Results: Strain JD-09 was screened and identified as Bacillus subtilis. The strain exhibited a maximum chitinase production of 1.33 U/mL in colloidal chitin broth after 3 days of cultivation at 28 °C. The molecular weight of the chitinase was estimated to be 57 kDa, 39 kDa and 30.7 kDa. Hydrolysis products of the fungal cell wall by the purified enzymes of B. subtilis JD-09 were analyzed by high-pressure liquid chromatography (HPLC) and identified as oligosaccharides.
Conclusion: It can be interfered that Bacillus subtilis JD-09 may be an optimal candidate for use as an antifungal agent of Fusarium wilt in crops. The purified chitinase can be directly applied for suppressing growth of living fungal hyphae.
Keywords: Fusarium oxysporum, B. subtilis JD-09, chitinase, antifungal activity.
INTRODUCTION
Fungal pathogens can cause severe and invasive diseases in humans, animals and plants throughout the world. With increase in prevalence of pathogenic fungus, the search for novel antifungal agents is of utmost importance [1]. Several microorganisms are known to suppress the growth of pathogenic bacteria and fungi due to production of bioactive compounds [2]. Soil is an extensively explored ecological niche for sources of microorganisms that produce useful biologically active molecules. Among these microbes, bacteria are prolific source of novel compounds with fascinating antimicrobial activity [3,4]. Bacillus sp. Are among the important soil inhabitant bacteria that were instantly studied with regard to the production of bioactive compounds and have been extensively used as potential antimicrobial agents [5-7]. The promising antagonistic bacteria from the species of Bacillus hint at the incredible wealth of antimicrobial compounds, including peptide antibiotics [8-11] and hydrolytic enzymes [12,13]. There is increasing circumstantial evidence implicating the existence of bioactive molecules as chitinase that contribute to their antifungal activities. The soil borne B. subtilis JD-09 has a broad spectrum of antifungal activity and secretes a number of chitinolytic enzymes, including two N-acetyl-β-D-glucosaminidases and chitinase. Its antifungal activity has been demonstrated with Fusarium oxysporum in cotton using Tn5 mutants deficient in chitinolytic activity [14]. Hence, chitinolytic enzyme might be considered to have an important role in biological control of fungal pathogens.
Chitin (C8H13O5N)n is an unbranched long chain polymer of glucose derivatives, composed of β-1,4 linked units of the amino sugar N-acetyl-D-glucosamine (NAGA). It is a major component of the cell walls of filamentous fungi, speculated to play a vital role in fungal defence against harm and pressures [15]. The interest in chitin degrading enzymes and their application in management of fungal pathogens are significant. Chitinases (EC 3.2.1.14), a group of antifungal proteins, catalyse the hydrolytic cleavage of the β-1,4-glycoside bond present in the biopolymers of N-acetyl-D-glucosamine, mainly in chitin. Till date only a small percentage of the bioactive have been investigated worldwide. Although, searching for natural antifungal substances especially with new mode of action is still one of the promising areas of research and has bright potential in the field of pharmaceutical industry. It has frequently been reported that chitinase producing microorganisms, in particular antifungal strains, can lyse viable fungal hyphae, thereby releasing substantial level of oligomers and other substances [16-18]. In the present study, we report of a newly isolated bacterium B. subtilis JD-09 possessing strong chitinolytic activity, which exhibited an antagonism toward F. oxysporum. Moreover, the antifungal activity of the purified chitinase from strain JD-09 was also partially characterized.
Materials and Methods
Screening of bacteria
Soil samples were collected from different places of the crop field in Kanchipuram district, Tamil Nadu, India. Soils were serially diluted with sterile water until a dilution of 106 colony forming units (CFU) g-1 of soils, inoculated on colloidal chitin (CC) agar medium containing 0.5% colloidal chitin, 0.2% Na2HPO4, 0.1% KH2PO4, 0.05% NaCl, 0.1% NH4Cl, 0.05% MgSO4 7H2O, 0.05% CaCl2 2H2O, 0.05% yeast extract and 2% agar, and incubated at 30 °C for 3 days. Strains exhibiting a clear zone (degradation of chitin) around the colony were picked and further subjected to antifungal activity against F. oxysporum (MTCC 2480, Microbial Type Culture Collection (MTCC), IMTECH, Chandigarh, India) grown on potato dextrose agar (PDA) medium containing 0.5% colloidal chitin at 30 °C for 7 days.
Bacterial identification
To identify the bacterium, the polymerase chain reaction (PCR) was performed to amplify the 16S rRNA gene from the genomic DNA of strain JD-09 as described earlier [19]. The forward primer was 5’- TGGCTCAGAACGAACGCTGGCGGC-3’, and the reverse primer was 5’- CCCACTGCCTCCCGTAAGGAGT-3’. The temperature cycle was at 94 °C for 30 s, 55 °C for 1 min, and 72 °C for 1 min 30 s for 30 cycles and 5 min at 72 °C for final extension, in a Minicycler PTC 100 (MJ Research, Waltham, MA, USA). The PCR product was cloned in a pGEM-T easy vector (Promega, Madison, WI, USA). The nucleotide sequence of the 16S rRNA gene was sequenced by ABI Prism 377 DNA sequencer (PE Applied Biosystems, Foster City, USA). The obtained sequence was then subjected for BLAST search to identify the bacterial isolate using Genbank data base of NCBI (Bethesda, USA).
Chitinase assay
For determination of chitinase activities, strain JD-09 was grown in CC broth at 30 °C, and samples were taken at 1, 2, 3, 4, and 5 days. Each sample was centrifuged at 8,000 × g for 5 min and the supernatant was used for enzyme activities. Chitinase activity was determined by incubating 1 mL of culture supernatant with 1 mL of 1% colloidal chitin in a 0.05 M phosphate buffer, pH 7.0 at 37 °C for 1 h. After centrifugation of reaction mixture, the amount of N-acetyl-d-glucosamine released in the supernatant was determined by the standard method [20] using N-acetyl-d-glucosamine (GlcNAc) as a standard. GlcNAc present in 0.5 mL of aliquot of supernatant was determined by adding 0.1 mL of K2B4O7 and then boiled for 3 min in a water bath. The tubes were cooled and 3 mL of p-dimethylaminobenzaldehyde was added. Absorbance was read within 10 min at 585 nm against the blank prepared with distilled water without the enzyme presence. One unit of chitinase is defined as the amount of enzyme which releases 1 μM N-acetyl-d-glucosamine per hour under the conditions of the study.
Preparation of crude enzyme
Strain JD-09 was cultured in a 2000 mL Erlenmeyer flask containing 1000 mL of CC broth at 30 °C for 3 days in a shaking incubator (180 rpm). After centrifugation of the broth culture at 8,000 × g for 30 min, ammonium sulfate was added to the supernatant at 50% saturation, and the mixture was left overnight at 4 °C. The precipitate was centrifuged at 12,000 × g for 30 min and the pellet was resuspended in 50 mM Tris-HCl buffer [pH 8.0], and dialyzed against the same buffer for overnight. The dialyzate was concentrated by lyophilization, and the concentration of protein was determined using bovine serum albumin (Sigma, St. Louis, MO, USA) as the standard [21].
Purification of chitinase
Strain JD-09 was cultured in a 2000 mL Erlenmeyer flask containing 1000 mL of CC broth at 30 °C for 4 days in a shaking incubator (180 rpm). After centrifugation of the broth culture at 8,000 × g for 30 min, ammonium sulfate was added to the supernatant at 50% saturation, and the mixture was left overnight at 4 °C. The precipitate was centrifuged at 10,000 × g for 15 min and the pellet was resuspended in 50 mM Tris-HCl buffer [pH 8.0], and dialyzed against the same buffer for overnight. The dialyzed was loaded onto a DEAE Sepharose column, which was previously equilibrated with 2mM Tris-HCl at pH 7.8. All the fractions were collected separately and absorbance was read at 280 nm in a spectrophotometer. Each purification step was performed in 4 °C.
Electrophoresis
The concentrated enzyme sample was subjected to electrophoresis in 12% SDS-PAGE, according to the method described previously [22]. Subsequently, zymogram was demonstrated by copolymerizing 0.01% of glycol chitin (Sigma) in SDS-PAGE for the detection of chitinase activity [23].
Antifungal activity
The purified chitinase was assayed for antifungal activity against F. oxysporum by well diffusion assay on PDA plate. A fungal plug (6 mm diameter) was removed from the 5 day old culture. The plug was transferred onto the center of the PDA plate, which had been loaded with chitinase in the right well and the left well was loaded with same volume of buffer. The plate was incubated for 5 days at 30 ºC and was monitored for a zone of inhibition around the well.
Results and Discussion
Isolation and identification of antagonistic bacterium
In our pilot scale screening, various microbial colonies were able to degrade chitin on CC agar medium. Among these, a bacterial isolate that exhibited the maximum halo zone around the colonies, was designated to be the strain JD-09 (Fig. 1).
Fig. 1: Growth of chitinolytic bacteria on colloidal chitin agar (CCA) medium at 28 °C for 3 days.
Subsequent antimicrobial activity was examined through dual plate assays using various phytopathogens. Interestingly, strain JD-09 exhibited a strong antifungal activity against F. oxysporum (Fig. 2).
Fig. 2: Inhibition of the growth of F. oxysporum by strain JD-09 on potato dextrose agar (PDA) medium containing 0.5% of colloidal chitin at 28ºC for 3 days.
From the morphologic and biochemical observation, strain JD-09 was found to be a Gram-negative, rod-shaped and polar-flagella bacterium with permissive temperature ranging between 20 ºC to 37 ºC with an optimum at 30 ºC.

Fig. 3: Phylogenetic location of strain JD-09 based on 16S rRNA sequences by Neighbor-joining method program.
The genomic DNA of the strain JD-09 was amplified with universal primers and 16S rRNA gene sequence was analyzed. Alignment of this sequence (838) through matching with reported 16S rRNA gene sequences in the Genbank showed high similarity (99 to 100%) to Bacillus subtilis sp. The phylogenetic tree determined by the Neighbour-joining method showed that Bacillus sp. and B. subtilis were most closely related to strain JD-09 (Fig. 3).

Fig. 4: Determination of chitinolytic activity by Bacillus subtilis JD-09 in CC broth medium at 30 ºC for 5 days. Mean values were 3 replicates. Bars represent standard error.
On the basis of these results, strain JD-09 was identified as a member of Bacillus subtilis sp, and designated as B. subtilis JD-09 (Genbank accession number JX628752). Members of the genus Bacillus are ubiquitous in soil microorganisms. They are believed to serve as the promising group of antifungal agents and have been widely evaluated with the production of chitinases [25-29].
Determination of chitinolytic activity
B. subtilis JD-09 was investigated for the production of extracellular chitinase in CC broth by spectrophotometry. At 24 h intervals, aliquots of cell cultures were taken, and the chitinase activity was determined by standard method. The results from culture filtrate of strain JD-09 exhibited maximum chitinase activity of 1.33 U/mL after 3 days of cultivation and gradually decreased thereafter (Fig. 4).
Purification of chitinase
The chitinase was purified from culture broth of B. subtilis JD-09 strain by ammonium sulphate precipitation followed by DEAE-Sepharose (anion exchange), and Sepharose G-100 (gel filtration). After ammonium sulphate precipitation, the concentrated supernatant exhibited chitinase activity. The anion exchange chromatography yielded a single peak that could be detected at 280 nm. The peak with chitinase activity was further purified by gel filtration chromatography and results were summarized in Table 1.
Table 1: Summary of the steps in chitinase purification from Bacillus subtilis JD-09
| Purification step | Total Protein (mg) | Total activity (U) | Specific activity (U.mg-1) | Purification (n-fold) | Yield (%) |
| Culture filtrate | 70.6 | 976 | 25.8 | 1.3 | 100 |
| NH4(SO4)2 precipitate | 29.8 | 701 | 54.9 | 2.4 | 70 |
| DEAE cellulose | 5.1 | 311 | 174 | 6.7 | 22 |
The data indicate that chitinase produced by B. subtilis JD-09 strain was purified to 8.2-fold with an overall yield and specific activity of 12% and 198 units/mg, respectively. The final amount of chitinase obtained was 1.6 mg from 1 litre of broth culture.
SDS-PAGE and zymogram
The molecular weight of purified chitinase was determined by gel electrophoresis using standard marker. The purified samples of strain JD-09 revealed several bands on 12% SDS-PAGE and the chitinase activity were identified as 56 kDa by zymogram (Fig. 5). The molecular weights of bacterial chitinases ranged from 20,000 to 120,000 kDa with little consistency. Different molecular masses have been reported for other bacterial chitinases as well [30,31].

Fig. 5: 10% SDS-PAGE and zymogram of chitinase obtained from culture supernatant of Bacillus sp. JD-09.
Lanes 1 and 2 were obtained from SDS-PAGE of Coomassie brilliant blue R-250 where lane 1 is molecular weight (MW) of standard markers in kilodaltons (kDa), and lane 2 is purified chitinase sample. Lane 3 indicates zymogram demonstrated by copolymerizing 0.1% of glycol chitin.
Analysis of antifungal activity
Fusarium wilt is a widespread plant disease caused by many forms of the soil-inhabiting fungus F. oxysporum. Several attempts have been made to exploit the biological control of F. oxysporum by chitinase producing bacteria. Inhibitory effect on the growth of hyphae of F. oxysporum was investigated under different concentration of purified chitinase by well diffusion assay on PDA plate and a concentration of 50 μl (2.0 U/mL) yielded the maximum inhibition against F. oxysporum (Fig. 6).
Fig. 6: Antifungal activity of chitinase against F. oxysporum by well diffusion assay on potato dextrose agar (PDA) at 30 °C for 5 days. Right well was loaded with chitinase and the left well loaded with same volume of buffer.
However, in control well, the same volume of sodium acetate buffer did not inhibit the pathogen. Microscopic observation revealed morphology of hyphae that appeared as swelled, fragmented and distorted in the wells treated with the enzyme, whereas the hyphae from the control were normal and intact without any distortion (data not shown). The results presented here support antibiosis as the mechanism of antagonism against F. oxysporum by strain JD-09 mediated through chitinase production. Several studies have demonstrated that chitinases of potential antifungal strains can cause deformation of viable hyphae and result in inhibition of hyphae of the test fungi [27-29]. Then, the purified chitinase was further assayed for antimicrobial activity against various microorganisms.
Conclusion
From the results presented in this experiment, we draw a positive correlation can be inferred between the production of chitinase and suppression of the growth of F. oxysporum. However, it is necessary to study the secretion of other lytic enzymes as well, especially cellulase, β-1,3-glucanase, and laminarinase, as chitinase may combine with other lytic enzymes to exhibit synergism, and result in high levels of antifungal activity. Therefore, we suggest that Bacillus subtilis JD-09 may be an optimal candidate for use as an antifungal agent of Fusarium wilt in crops, but further studies are needed to evaluate more extensively this possibility.
CONFLICT OF INTERESTS
Declared None
Acknowledgment
Authors are thankful to the Management and Department of Biotechnology, SRM University for providing necessary facilities and encouragement.
References